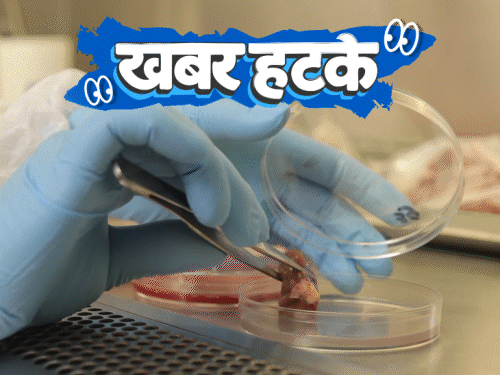

जापानी वैज्ञानिकों ने ऐसी दवा खोजी है, जिससे हर इंसान 100 सालों से ज्यादा जिंदा रह सकेगा। वहीं यूरोप में पेड़ों की पत्तियों से सोना निकल रहा है। तो ये थी आज की रोचक खबरें, कल फिर मिलेंगे कुछ और दिलचस्प और हटकर खबरों के साथ… ************* रिसर्च सहयोग: रागिनी राय खबर हटके को और बेहतर बनाने के लिए हमें आपका फीडबैक चाहिए। इसके लिए यहां क्लिक करें…